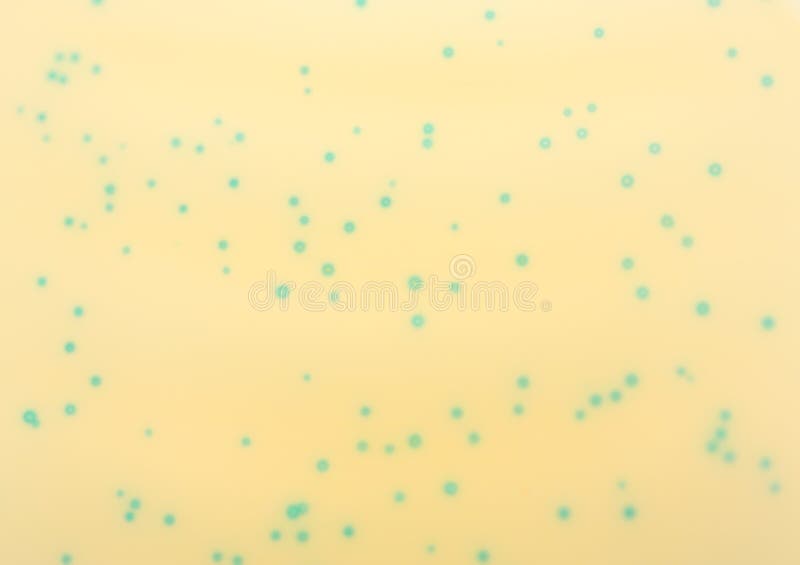
Blue Bacteriophage Plaques royalty free stock images
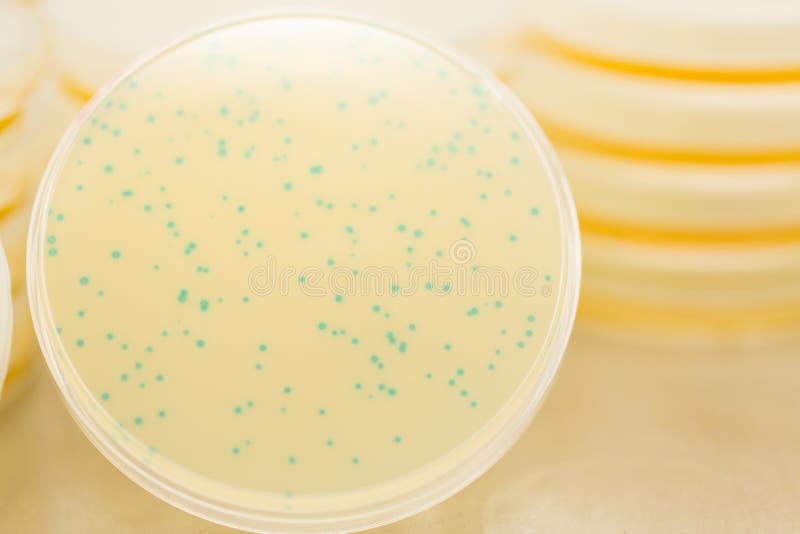
Blue Bacteriophage Plaques royalty free stock photo

Royalty-Free Stock Photo
Assay plate 96 well with colourful buffer. Plate for chemical analysis such as antioxidant tests with different concentrations
2
1
- ?
$75.00USD
$180.00USD
$300.00USD
Size MAX
5760x3840px •
19.2" x 12.8" • @300dpi •
12.1MB • jpg
Author credit line